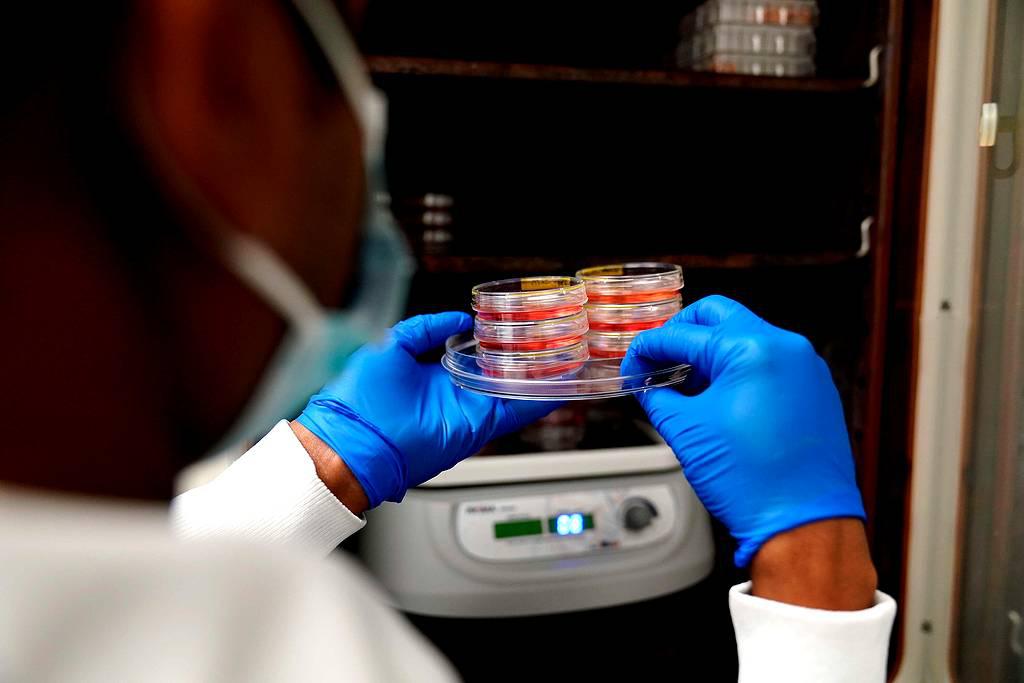

علم الوراثة يقتفي 10 آلاف عام من تطور مناعتنا
باريس - إنها ثورة وراثية تعود إلى العصر البرونزي في أوروبا: قبل 4500 عام، بدأ جهاز المناعة لدى الإنسان التحوّر لمقاومة انتشار أمراض معدية بشكل أفضل، على حساب حمايتنا ضد أنواع أخرى من الأمراض.
تتعقب دراسة نُشرت الجمعة تطور التحوّرات الجينية خلال الـ10 آلاف عام الماضية، أي منذ العصر الحجري الحديث عندما تخلى الصيادون عن حياة الترحال التي كانوا يعيشونها لتطوير الزراعة وتربية الماشية.
حلّل العلماء الحمض النووي القديم لـ2300 فرد أوروبي عُثر عليه خلال عمليات حفر أثرية مختلفة، وخزّن في قاعدة بيانات. ودمجوا هذه العينات مع 500 مجين حديث وطوّروا طريقة لتحديد وتأريخ الاختلافات الجينية التي حدثت مع مرور الوقت، في نهج قائم على تسلسل جين الإنسان البدائي، وهو تخصص فاز عنه بجائزة نوبل الطب لعام 2022 عالم الأحياء السويدي سفانتي بابو.
ومن بين مئات الآلاف من التحوّرات المستخلصة، حدّد الباحثون أن بعضا منها "مفيد في مكافحة العدوى".
وهذه التحوّرات موجودة في 89 جيناً، كما شرح لويس كوينتانا-مورسي، مدير الدراسة المنشورة في مجلة "سيلز جينومكس".
كذلك، اكتشف العلماء تواترا متزايدا لهذه الجينات الـ89، التي لها دور في استجابتنا المناعية ضد مسببات الأمراض، كما أضاف هذا الأستاذ في معهد باستور وكوليج دو فرانس.
شعوب يامنايا
وازدادت هذه التحوّرات المفيدة لبقائنا على مر العصور، بفضل اختيار "إيجابي" لتكيف البشر مع البيئة.
وقال كوينتانا-مورسي إن الاكتشاف الثاني يتمثل في أنه "نجحنا في التأريخ بدءا من الوقت الذي أصبحت فيه مفيدة، وتحديدا منذ 4500 عام، اعتبارا من العصر البرونزي".
وهذا التاريخ يتزامن مع "وصول الهجرة الكبرى من سهول آسيا الوسطى، لشعوب يامنايا التي أتت بلغات الهندو-أوروبية والتي يحمل جميع الأوروبيين اليوم آثارا وراثية منها"، كما أوضح هذا الخبير في الوراثة السكانية.
وقد أدت هذه الهجرة إلى نمو كبير في عدد السكان الأوروبيين ووفرت أرضا خصبة لانتشار الميكروبات المسببة للأمراض.
واستبعدت الدراسة أن تكون شعوب يامنايا جلبت معها مسببات أمراض جديدة بدليل أن "التحوّرات الجينية كانت موجودة أصلا قبل هذه الهجرة، لكنها كانت غير نشطة لأنه لم يكن هناك العديد من الأمراض. مع النمو السكاني أصبحت مفيدة لمكافحة العدوى" كما شرح المؤلف.
"ثمن"
لكن كان هناك "ثمن كان يجب دفعه". ففي حين ازدادت حمايتنا من الأمراض المعدية، جعلتنا هذه التحوّرات نفسها "أكثر عرضة" لأمراض المناعة الذاتية، مثل مرض كرون أو الذئبة أو التهاب المفاصل الروماتويدي وكذلك الأمراض الالتهابية.
جعلتنا هذه التحوّرات نفسها أكثر عرضة" لأمراض المناعة الذاتية
وهذه أمراض تقتل أقل بكثير من الأمراض المعدية، وهو ما يفسر تكيّف مناعتنا مع الخطر الأكبر.
وقال كوينتانا-مورسي "كنا نعلم أن نظامنا أصبح أقل مقاومة لأمراض المناعة الذاتية والالتهابات، لكننا لم نكن نعلم أن هذا يعود إلى مطلع العصر البرونزي".
وذلك يدحض الفرضية الصحية التي تقول إن وصول اللقاحات والمضادات الحيوية في القرن العشرين هو ما ساهم في تطور أمراض المناعة الذاتية والالتهابات، في مقابل انخفاض انتشار الأمراض المعدية.
وبسبب نقص العيّنات الكافية في القارات الأخرى، لم يتمكّن معدو الدراسة من معرفة ما إذا كان هذا التطور هو نفسه في سائر أنحاء العالم.
لكن اكتشافهم قد يفتح مجالا للبحث الطبي من خلال تطوير علاجات تستهدف جينات معينة.